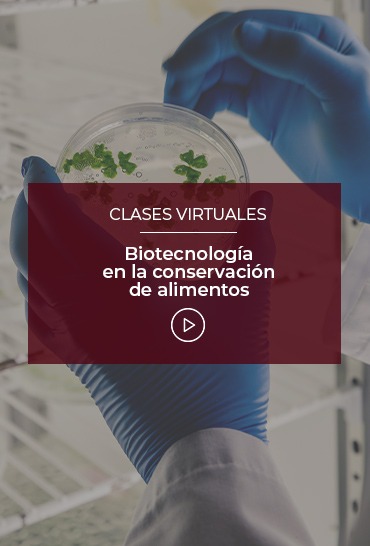

People Analytics: descripción, beneficios y métricas
People Analytics, también conocido como HR Analytics o analítica de personas es un método de análisis basado en datos, cuyo objetivo es estudiar todos los procesos, funciones, tendencias y desafíos que involucran a los profesionales de una organización. La finalidad de esta herramienta es aumentar el rendimiento y optimizar todos aquellos aspectos que pueden mejorar.
También se dice que esta técnica consiste en recopilar y transformar todos los datos obtenidos del área de recursos humanos en conocimientos prácticos que no solo mejoran la experiencia de los empleados, sino también los resultados del negocio.
Para comprender estos datos se utilizan gráficas, tablas e infografías elaboradas por el propio departamento. Se trata, por lo tanto, de una metodología basada en las matemáticas, la estadística y la modelización, que permite observar evidencias y detectar patrones sobre el comportamiento, el desempeño y los resultados obtenidos por parte de los miembros de una organización. ¿Queréis saber más? En el webinar de hoy os lo explicamos.